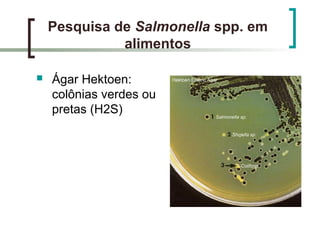
Pesquisa de Salmonella spp. em
alimentos
 Ágar Hektoen:
colônias verdes ou
pretas (H2S)

O documento descreve uma pesquisa sobre Salmonella spp. em alimentos. Resume os principais pontos sobre a taxonomia, características, distribuição ambiental, doenças causadas e métodos de isolamento e identificação da bactéria Salmonella, incluindo enriquecimento seletivo, plaquing seletivo, triagem bioquímica e sorologia.